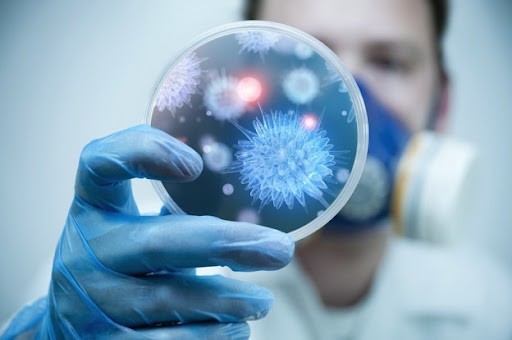
Bạc được dùng làm kháng sinh sinh học

Nội dung bài viết
Trang sức bạc cũng là sản phẩm rất được ưa chuộng hiện nay, đặc biệt là đối với phái đẹp vì so với vàng, kim cương và đá quý thì bạc có mức giá hợp lý hơn rất nhiều. Và trong bài viết hôm nay chúng ta sẽ cùng nhau tìm hiểu sâu hơn để biết ý nghĩa của bạc cũng như mục đích sử dụng của bạc trong cuộc sống nhé.
Ý nghĩa của bạc đối với sức khỏe con người
Bạc tuy cũng nằm trong nhóm kim loại nặng cùng với chì, vàng, thủy ngân và cadimi nhưng lại không chứa những độc tố gây hại cho sức khỏe con người và các sinh vật sống khác như các kim loại khác. Ngay từ xa xưa đã có nhiều kết luận cho rằng bạc, ion bạc có khả năng đào thải độc tố.
Trong y học, Hippocrates – cha đẻ của y học – đã sử dụng bạc để chữa bệnh vì theo ông, bạc có đặc tính ngăn ngừa và chống lại một số bệnh nhất định. Trong Thế chiến thứ nhất, trước khi có thuốc kháng sinh, bạc là loại thuốc chống lại bệnh tật trên chiến trường. Năm 1920, dung dịch muối bạc được FDA (Mỹ) phê duyệt là chất kháng khuẩn.

Muối bạc được dùng làm chất kháng khuẩn
Chỉ với một lượng nhỏ nồng độ khoảng 0,1 – 0,01mg/l, bạc còn có thể tiêu diệt hầu hết các loại vi khuẩn gây bệnh ở người, trong đó có 2 loại vi khuẩn: Staphylococcus aureus (staphylococcus aureus) gây nhiễm trùng và nhiễm trùng da và Escherichia Coli (E. Coli) gây nhiễm trùng đường tiết niệu và các bệnh về đường ruột. Nguyên nhân là do ion Ag+ có tính oxi hóa rất mạnh. Khi ở dạng dung dịch, nó có thể tiêu diệt 260 loại vi trùng, vi khuẩn, nấm mốc….
Ngày nay, trong y học hiện đại, bạc được dùng để chữa nhiều bệnh, trong đó có nội khoa, da liễu, bệnh về đường hô hấp, viêm mũi họng, các bệnh về cơ xương khớp, dị ứng và tăng cường hệ miễn dịch. Một ví dụ cụ thể là bạc sulfadiazine ở dạng kem dùng để bôi lên da nhằm ngăn ngừa và điều trị nhiễm trùng khi bị bỏng. Hoặc bạc nitrat được dùng để chấm chồi rốn do nhiễm trùng vì nó có khả năng làm co các u hạt, khiến chúng không còn tiết dịch và xẹp dần.

Bạc được dùng chữa nhiều bệnh
Với đặc tính giúp mạch máu co giãn đàn hồi, bạc rất quan trọng trong việc hình thành xương, làm lành sẹo và phục hồi da nhanh chóng.
Khi phản ứng với chất độc, bạc sẽ đổi màu nên bạn có thể dùng nó để kiểm tra xem thực phẩm, đồ uống có chứa chất độc hại hay không. Trong triều đình xưa, bạc được dùng làm bát, đũa cho vua chúa để tránh ngộ độc thực phẩm.
Bạc được dùng làm kháng sinh sinh học thay cho kháng sinh y học thông thường vì nó có khả năng diệt khuẩn có chọn lọc, không tiêu diệt vi khuẩn có lợi, khiến vi khuẩn không thể kháng thuốc trở lại mà không gây kháng thuốc và làm suy yếu hệ miễn dịch. Là một ion hòa tan, bạc dễ dàng xâm nhập vào màng tế bào vi khuẩn hơn, từ đó cản trở và ức chế quá trình trao đổi chất của tế bào, ngăn cản vi khuẩn tạo ra kháng thể. Điều tuyệt vời là cơ chế này không có bất kỳ tác động nào đến tế bào của con người nên trở thành một loại kháng sinh sinh học rất an toàn cho sức khỏe nếu sử dụng đúng cách.
Bạc được dùng làm kháng sinh sinh học
Các loại bạc được sử dụng làm đồ trang sức hiện nay
– Bạc nguyên chất hay còn gọi là bạc ta. Loại này chứa tới 99,9% hàm lượng bạc. So với các loại bạc khác, bạc khi chưa được đánh bóng có màu trắng đục và mềm hơn.
– Bạc 925 (Bạc Ý): Là loại bạc chứa 92,5% bạc và 7,5% kim loại quý khác nhằm tăng độ sáng bóng và độ cứng. Đây cũng là loại bạc có độ sáng bóng và độ trắng tốt nhất trong số các loại bạc.
– Bạc đánh bóng: Là loại bạc có chứa 92,5% bạc nguyên chất và được mạ thêm một lớp kim loại quý bên ngoài, giúp tăng độ bền, vẻ đẹp, độ cứng và độ lấp lánh. Lớp mạ này thường là vàng trắng, vàng vàng hoặc vàng hồng.
– Bạc Thái: Bạc Thái cũng giống như bạc Ý, có độ cứng cao, dễ dàng chế tác thành những đồ trang sức đẹp, tinh xảo nhưng so với bạc 925 thì nó vẫn có một số đặc tính khác.

Các loại bạc được sử dụng làm đồ trang sức hiện nay
Cách kiểm tra bạc nguyên chất
Mặc dù là kim loại quý, có màu trắng sáng và bền với nhiều hóa chất, tác nhân oxy hóa nhưng bạc nguyên chất lại rất mềm và dẻo nên không thể chế tác thành đồ trang sức. Chúng phải được kết hợp với một số hợp kim khác để tạo ra độ cứng. Vì vậy, các mặt hàng trang sức hầu như không được làm từ bạc nguyên chất 100% mà có lẫn thêm các kim loại khác. Dựa vào đặc tính của bạc nguyên chất là rất khó bị oxy hóa trong điều kiện bình thường và rất mềm, trong khi đó các hợp kim bạc lại dễ bị oxy hóa hơn, trong đó có hợp kim bạc đồng và bạc 925, chúng ta có thể kiểm tra bạc có nguyên chất hay không bằng một trong các cách sau:
– Thử lửa: Đây là phương pháp được sử dụng phổ biến nhất vì bạc không dễ bị oxy hóa ngay cả ở nhiệt độ cao. Bạn chỉ cần đun bạc đến khi nóng đỏ rồi để nguội hoặc nhúng vào nước nguội để biết đó có phải là bạc nguyên chất hay không. Cụ thể, nếu bạc không đổi màu hoặc chuyển sang màu đen thì đó là bạc thật hoặc bạc có tỷ lệ tạp chất rất thấp. Nếu bạc đổi màu thì đó là bạc kém chất lượng và chứa nhiều tạp chất.
– Kiểm tra âm thanh: Khi bạc thật rơi xuống sàn gạch hoặc bề mặt kim loại phẳng sẽ chỉ phát ra tiếng click mà không cộng hưởng, giống như tiếng nặng của sắt, thép, inox…
– Tác động lực: Vì bạc thật rất mềm nên khi tác dụng lực mạnh sẽ dễ bị biến dạng.

Cách kiểm tra bạc nguyên chất
Như vậy bài viết trên đã giúp bạn có cái nhìn đầy đủ hơn về ý nghĩa của bạc cùng một số thông tin thú vị khác về chúng. Để bài viết này được hoàn thiện hơn, chúng tôi rất mong nhận được ý kiến đóng góp của độc giả ở phần đánh giá, bình luận bên dưới. Cảm ơn quý độc giả đã quan tâm và theo dõi.

Nội dung được phát triển bởi đội ngũ truongchuvananhue.edu.vn với mục đích chia sẻ và tăng trải nghiệm khách hàng. Mọi ý kiến đóng góp xin vui lòng liên hệ tổng đài chăm sóc: 1900 0000 hoặc email: hotro@truongchuvananhue.edu.vn